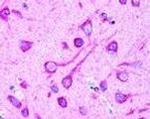
LC3B Antibody in Immunohistochemistry (IHC)

Search
Invitrogen
LC3B Polyclonal Antibody, Biotin
{{$productOrderCtrl.translations['antibody.pdp.commerceCard.promotion.promotions']}}
{{$productOrderCtrl.translations['antibody.pdp.commerceCard.promotion.viewpromo']}}
{{$productOrderCtrl.translations['antibody.pdp.commerceCard.promotion.promocode']}}: {{promo.promoCode}} {{promo.promoTitle}} {{promo.promoDescription}}. {{$productOrderCtrl.translations['antibody.pdp.commerceCard.promotion.learnmore']}}
产品信息
PA5-22709
宿主/亚型
分类
类型
抗原
偶联物
形式
浓度
规格
保存条件
运输条件
RRID
产品详细信息
This antibody has 92% homology with mouse, 91% with bovine, and 84% with xenopus.
Reacts weaker with mouse than with human samples
靶标信息
LC3B (Autophagy Marker Light Chain 3B, MAP1A/MAP1B LC3 B) in humans, is encoded by the gene MAP1LC3B (Microtubule-associated proteins 1A/1B light chain 3B). LC3B is associated with microtubule assembly and important is in neurogenesis. Recent studies indicate that LC3B plays a vital role in autophagy, a process that involves the bulk degradation of cytoplasmic component. Three human LC3 isoforms undergo post-translational modifications during autophagy. Macroautophagy is the major inducible pathway for the general turnover of cytoplasmic constituents in eukaryotic cells, it is also responsible for the degradation of active cytoplasmic enzymes and organelles during nutrient starvation. Macroautophagy involves the formation of double-membrane bound autophagosomes which enclose the cytoplasmic constituent targeted for degradation in a membrane bound structure, which then fuse with the lysosome (or vacuole) releasing a single-membrane bound autophagic bodies which are then degraded within the lysosome (or vacuole). LC3B is a microtubule-associated protein that mediate the physical interactions between microtubules and components of the cytoskeleton. LC3B may play a role in processes involving cancer, aging, metabolic and neurodegenerative disorders and cardiovascular/pulmonary diseases.
仅用于科研。不用于诊断过程。未经明确授权不得转售。